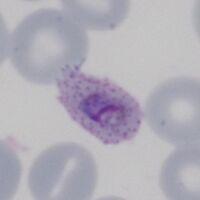
Solid parasite, red cell fimbriation ("comet form")
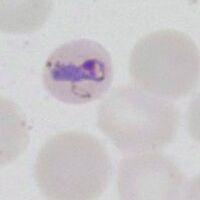
Early elongated form, small red cell
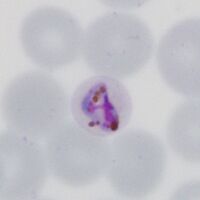
Angularity form

Gallery of late trophozoites
From MalariaETC
Navigation
>Main Malaria Index
>>Galleries Index Page
>>>Current page: Gallery of late trophozoites
Gallery of Late Trophozoites
Late trophozoites often have "species-specific" changes that affect parasite, red cell shape or added dots. These may be very helpful in assigning diagnosis, although not all changes are fully specific to a single species.
P.falciparum
The key features here are a slight thickening of ring forms but with the same appearances as early trophozoites. Additionally look for Maurer's dots and clefts appearning.
-
Two parasites, Maurer's dots and clefts
-
Double dot form with Maurer's dots
-
Accolé and double dot forms
-
Accolé parasite form
"
P.vivax
Ring forms are replaced with irregular and "amoeboid" forms. Red cells and parasites become markedly larger with distortion of red cells as they develop. Schüffner's dots and pigment becomes prominent.
-
Large very irregular ring, Schüffner's dots
-
Amoeboid parasite, distorted red cell
-
Amoeboid appearance of parasite
-
Very large amoeboid form diffuse pigment
"
P.ovale
Cells and parasite enlarge, but ring form is often retained, red cells are a little enlarged with ovoid form and prominent James' dots.
-
Ring form retained, fimbriation and dots
-
Ring form retained, ovoid red cell
-
Solid parasite, red cell fimbriation ("comet form")
-
Solid parasite, red cell fimbriation
"
P.malariae
Infected red cells may be infrequent. Parasites may become more solid and angular, or become elonagated and may extend across the red cell (band appearance). Red cells remain round and may be small, added dots (Ziemann's dots) are rarely seen.
-
Early elongated form, small red cell
-
A full band across the red cells
-
An open angular parasite, note pigment
-
Angularity form
"
P.knowlesi
Late trophozoite forms may still resemble P.falciparum but also develop features of P.malariae, although number may be high and dots (Sinton and Mulligan's stippling) are more likely to be seen.
-
Mixed irregular rings sparse dots
-
Elongated parasite forms
-
Solid and angular forms
-
Mixed forms, dots and pigment